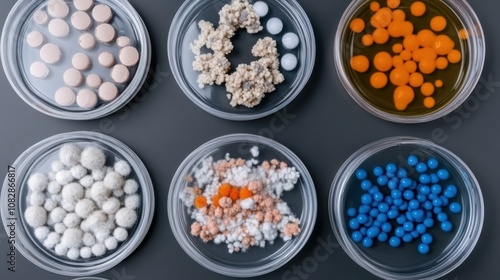

Download Muster
Download Muster
Datei Details
Veröffentlicht: 2024-11-15 19:39:20.541920
Kategorie: Food
Typ: Foto
Model release: NEIN
Share
Overhead view of petri dishes containing vibrant and diverse colonies of microorganisms, showcasing scientific exploration and biological diversity.
Schlüsselwörter
microbiology,
colony,
diversity,
overhead,
science,
biology,
laboratory,
colourful,
exploration,
research,
experiment,
texture,
growth,
culture,
observation,
vibrant,
cellular,
scientific,
analysis,
discovery,
nature,
life,
sample,
study,
microscopic,
innovation,
pattern,
variety,
organism,
investigation,
detail,
petri,
dish,
specimen,
cell